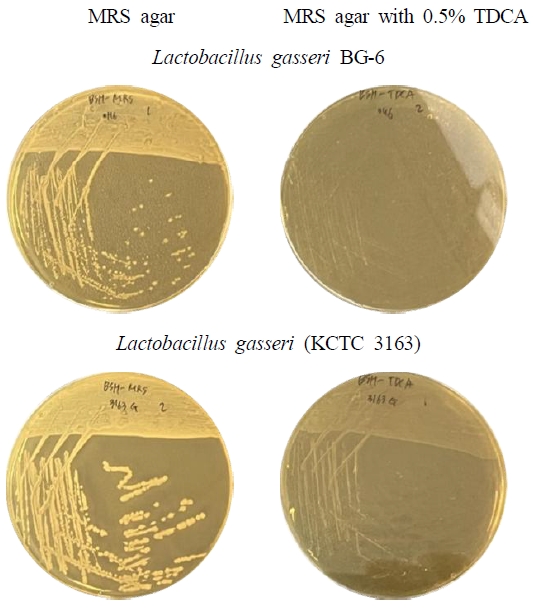
Fig. 4.

모유 수유 영아 분변 유래 Lactobacillus gasseri BG-6의 안전성 및 기능성 평가
Abstract
This study isolated lactic acid bacteria from the feces of a 40-day-old breast-fed infant and screened the sample for any probiotic potential. Among ten morphologically distinct colonies, Lactobacillus gasseri BG-6 showed the highest DPPH radical scavenging activity (98.40%) compared to 1 mM L-ascorbic acid (95.43%). Safety assessments indicated γ-hemolysis (non-hemolytic) on 5% sheep blood TSA and negative bile salt hydrolase on 0.5% TDCA-MRS. BG-6 tolerated the simulated gastric (pH 2.0±0.3% pepsin; 4 h survival 93.19% and 91.95%) and bile conditions (0.3% bile; survival 84.83% at 6 h and 60.33% at 24 h). Antibiotic testing suggested susceptibility to ampicillin, vancomycin, gentamicin, erythromycin, and tetracycline, with resistance to kanamycin and clindamycin; streptomycin and chloramphenicol were borderline to the EFSA cut-offs. Collectively, BG-6 exhibited a favorable safety profile and gastrointestinal robustness, supporting its candidacy as a probiotic ingredient. Future work will genotype resistance determinants and mobile elements via whole-genome sequencing and deposit the strain in a public culture collection.
Keywords:
Lactobacillus gasseri, breast-fed infant feces, probiotics, safety서 론
인간의 몸에서 공생하고 있는 미생물은 인체 생리의 핵심 요소로 작용하며, 인간 세포 수와 미생물 수의 비율은 대략 1:1 수준에 가깝다(Sender R 등 2016). 이러한 미생물 집단은 미생물총(Microbiota)이라 불리며, 이는 구강, 피부, 장내 등과 같이 특정 환경에서 발견되는 살아있는 미생물의 군집을 의미한다(Hou K 등 2022). 이 중 특히 음식을 섭취하고 소화를 진행하는 위장관에는 약 1013∼1014(10조∼100조)개의 미생물이 서식하고 있으며, 이는 전체 인체 미생물총의 대부분을 차지한다(Johnson CL & Versalovic J 2012). 인간의 장내 미생물총은 영양소 소화와 흡수는 물론, 면역 반응 조절, 염증 및 대사 조절 등에 중요한 역할을 하며, 이의 조성과 균형이 건강과 질병에 영향을 미친다. 이러한 미생물총은 단순한 공생 생물체를 넘어 “숨겨진 장기”라고도 불릴 만큼 그 중요성이 강조되고 있다(Hou K 등 2022). 그러나 환경적 요인, 식습관, 항생제 사용 등 여러 요인으로 인해 장내 미생물총 불균형이 발생할 수 있으며, 이는 다양한 대사 질환 및 면역 질환으로 이어질 수 있다(Rinninella E 등 2019). 특히 영아기의 장내 미생물총 형성은 단순히 영유아기뿐만 아니라 생애주기 전체에 걸친 건강의 방향성을 결정짓는 중요한 역할을 한다. 출생 직후부터 신생아는 다양한 경로를 통해 외부 미생물에 노출되며 이 시기에 정착되는 미생물총의 군집화는 다양한 만성 질환의 발생에 영향을 미친다(Milani C 등 2017).
따라서 이러한 미생물총의 불균형을 예방하고 조절하는 전략 중 하나로 프로바이오틱스의 활용이 주목받고 있다(Bhatia A 등 2025). 프로바이오틱스란 적절한 양으로 섭취하면 숙주의 건강에 도움이 되는 살아있는 미생물을 말한다(FAO & WHO 2002). 프로바이오틱스는 일반적으로 장 건강 개선, 면역력 강화, 소화 기능 향상, 피부 및 정신 건강 개선 등 여러 유익한 기능을 가지고 있는 것으로 알려져 있다(Jang SE & Min SW 2019; Ali M 등 2025; Jeong JW 등 2025; Khanzadeh M 등 2025; Li W 등 2025). 프로바이오틱스는 다양한 균속과 균종으로 구성되어 있으며 대표적으로는 Lactobacillus, Lacticaseibacillus, Bifidobacterium, Enterococcus, Streptococcus 속 등이 있다(Gupta V & Garg R 2009). 이 중 특히 Lactobacillus 속은 우수한 장내 정착력과 항균능력 등 유익한 생리적 기능이 뛰어나 여러 연구와 건강기능식품에 많이 활용되고 있다(Tuomola EM & Salminen SJ 1998; Slover CM & Danziger L 2008; Shim YH 등 2016). 이러한 프로바이오틱스들은 여러 분리원에 존재하며 일반적으로 인간에게 사용되는 프로바이오틱스의 분리원의 경우 식품 유래와 인체 유래 등으로 나눌 수 있다. 식품 유래 프로바이오틱스는 주로 유제품과 발효식품 등에서 분리되며, 인체 유래 프로바이오틱스는 구강, 모유, 분변 등에서 분리된다(Fontana L 등 2013).
이 중 최근에는 모유와 영아 분변에서 유래한 유산균이 장내 환경에 보다 잘 정착한다는 연구들이 발표되며 주목받고 있다(Wang X 등 2021; Wu Y 등 2024). 특히 모유 수유는 장내 미생물 군집을 확립하는 데 중요한 시기인 영아기의 장내 미생물의 다양성 확보에 긍정적인 영향을 준다(Davis EC 등 2022). 더불어 임신 중 산모가 섭취한 프로바이오틱스가 태아 또는 수유기를 통해 영아에게 직접적으로 전달된다는 가능성이 제기되며, 프로바이오틱스의 모자 간 수직 전이에 관한 연구 또한 활발해지고 있다(Rautava S 2016). 이는 산모가 섭취한 프로바이오틱스가 태아 및 신생아의 장내 미생물총 환경 형성에 기여할 수 있다는 점에서 중요한 의미를 지닌다(Schultz M 등 2004). 이에 따라서 모유 수유 영아의 분변에서 분리한 프로바이오틱스 또한 그 기능성이 우수하다는 연구 결과가 늘어나고 있는 실정이다(Davoodabadi A 등 2015; Zuo F 등 2016). 그러나 영아 분변에서 분리된 프로바이오틱스, 특히 L. gasseri의 기능성이 일부 보고되어 있음에도 불구하고 특정 균주 수준에서 안전성, 항산화능, 장내 생존성을 통합적으로 평가한 연구는 여전히 부족하다. 특히 임신 중 산모가 섭취한 프로바이오틱스가 모유를 통해 영아로 전달되는 경로는 기존 연구에서 다루어진 일반적인 분리원과는 생태적 배경이 다르기 때문에, 해당 조건에서 장내에 정착한 유산균은 기존 보고된 균주와 기능적 특성이 달라질 가능성이 있다. 이러한 점에서 영아 분변 유래 프로바이오틱스를 균주 수준에서 체계적으로 평가하는 연구는 학문적·산업적 가치가 크며, 본 연구는 이러한 미생물 전이 경로를 가진 프로바이오틱스의 기능성과 안전성을 통합적으로 검증함으로써 기존 연구의 한계를 보완하고자 한다.
이에 본 연구에서는 임신 중 프로바이오틱스를 섭취한 산모의 모유를 수유한 신생아의 분변에서 새로운 유산균을 분리하고, 선별한 균주의 안전성과 기능성을 평가하였다.
재료 및 방법
1. 실험 재료 및 시약
본 연구에서 균 실험을 위한 autoclave, clean bench incubator는 Biofree(Seoul, Korea)에서 구입하였다. 집균을 위한 high-speed microcentrifuge는 Hanil Scientific(Gimpo, Korea)에서 구입하였다. 흡광도 측정을 위한 microplate spectrophotometer는 Thermo Fisher Scientific(Waltham, MA, USA)에서 구입하였다. 내산성 실험을 위한 pH meter는 Ohaus(Parsippany, NJ, USA)에서 구입하였다.
LAB 분리를 위한 Difco™ Lactobacilli MRS broth와 Bacto™ agar는 BD(Becton, Dickinson and Company, Sparks, MD, USA)에서 구입하였다. 분리 균주의 항산화능 평가를 위해서 2,2-diphenyl-1-picrylhydrazyl(DPPH)는 Alfa Aesar(Thermo Fisher Scientific, Waltham, MA, USA)에서 구입하였으며, 항생제 내성 평가에 사용된 ampicillin, vancomycin, gentamicin, kanamycin, streptomycin, erythromycin, clindamycin, tetracycline, chloramphenicol strip은 Liofilchem®(Roseto degli Abruzzi, Italy)에서 구입하였다. 용혈활성 평가를 위한 sheep blood는 Synergy Innovation(Seongnam, Korea)에서, BSH 활성 평가에 필요한 taurodeoxycholic acid(TDCA)는 MilliporeSigma(Burlington, MA, USA)에서 구입하였다. 내산성 평가에 필요한 sodium hydroxide(NaOH)와 hydrochloric acid (HCl)는 Samchun Chemical(Seoul, Korea)에서, pepsin은 Roche Diagnostics(Mannheim, Germany)에서 구입하였으며, 내담즙성 평가에 필요한 bile salts는 Sigma-Aldrich(St. Louis, MO, USA)에서 구입하였다.
2. 분변 시료 수집과 균주 분리
본 연구에서는 균주 분리를 위해 시료는 임신 기간 중 프로바이오틱스를 섭취한 산모의 모유를 수유한 생후 40일 된 영아로부터 분변을 채취하였다. 시료는 분쇄하여 멸균된 MRS broth로 10배 단계 희석하였다. 각 농도별 희석액을 100 μL씩 MRS 한천 배지에 도말하여 37℃에서 48 hr 동안 혐기성 조건으로 배양하였다. 이후 평판 배지에 배양된 colony를 색상, 크기 및 형태학적 특성을 비교하여 상이한 양상을 보이는 집락 10개를 각각 취하여 선별하고 프로바이오틱스 후보군으로 분리하였다. 분리주는 25% glycerol에 현탁하여 -80℃에 보존하였다.
3. 항산화능 평가
분리한 균주를 MRS broth에서 37℃, 24 hr 배양 후 원심분리(3,000 rpm, 10min)하여 상등액을 제거하였다. 균체는 PBS로 1회 세척 후 100 mg/mL이 되도록 PBS로 현탁하였다. 균주 현탁액을 0.2 mM DPPH(2,2-diphenyl-1-picrylhydrazyl) 용액과 1:1 비율로 혼합하고 37℃에서 10분간 반응시켰다. 이후 원심분리(13,000 rpm, 10 min)하여 상등액을 취한 후 Spectrophotometer를 이용해서 517nm에서 흡광도를 측정하였다. 양성 대조군으로는 1 mM L-ascorbic acid를 사용하였다. 항산화 활성은 아래와 같은 계산식을 이용하여 자유라디칼 소거능(%)으로 산출하였다.
- A1: 샘플+DPPH
- A2: 샘플+EtOH(샘플 블랭크)
- A3: DPPH+PBS(시약 대조군)
- A4: PBS+EtOH(용매 블랭크)
4. 항생제 내성 평가
선별된 균주의 항생제 내성은 E-test(epsilometer test)를 이용하여 평가하였다. 균주를 MRS broth에 37℃에서 24 hr 배양한 후, 새로 멸균한 MRS broth로 0.5∼1.0 McFarland(1.5∼3 × 108 CFU/mL) 농도가 되도록 희석하였다. 멸균 면봉을 이용하여 희석한 배양액을 MRS agar plate에 lawn이 형성되도록 streaking한 후, 항생제 strip을 배지 표면에 부착하고, 37℃에서 48 hr 동안 혐기적 조건으로 배양하였다. 배양 후, 스트립을 따라 형성된 저해환의 가장 밑 부분을 최소 저해 농도(minimum inhibitory concentration; MIC)로 판독하였다. 사용한 항생제는 EFSA(European Food Safety Authority)의 MIC cut-off value 기준에 따라 ampicillin, vancomycin, gentamicin, kanamycin, streptomycin, erythromycin, clindamycin, tetracycline, chloramphenicol로, 총 9가지를 사용하였다.
5. 용혈활성 평가
분리한 균주의 용혈활성은 TSA(tryptic soy agar) blood agar 배지를 이용하여 평가하였다. 분리된 균주는 MRS broth에서 37℃, 24 hr 배양 후 사용하였다. TSA 배지는 제조하여 멸균한 뒤 40∼50℃의 온도로 조정 후 5%의 멸균된 sheep blood를 첨가하였다. 배양액을 TSA blood agar 배지에 streaking하여 37℃, 48 hr 동안 혐기적 조건에서 배양하였다. 배양 후 형성된 집락의 형태를 투과광으로 관찰하여 α-hemolysis(녹색 콜로니 형성), β-hemolysis(투명한 콜로니 형성), γ-hemolysis(변화 없음)로 분류하여 용혈활성을 평가하였다.
6. Bile Salt Hydrolase(BSH) 활성 평가
BSH 활성 평가는 0.5% taurodeoxycholic acid(TDCA)가 첨가된 MRS agar plate를 이용하여 수행하였다. 분리 균주를 MRS broth에서 37℃, 24 hr 배양 후 배양액을 0.5% TDCA를 첨가한 MRS agar plate에 streaking하여 혐기적 조건에서 37℃, 48 hr 동안 배양하였다. TDCA를 첨가하지 않은 MRS agar plate를 대조군으로 사용하였으며, BSH 활성의 비교 균주로는 KCTC 3163(L. gasseri)을 사용하였다. 이후 bile salt deconjugation 생성 유무에 따라 BSH 양성 및 음성으로 판정하였다.
7. 내산성 및 내담즙성 평가
분리 균주의 내산성은 pH 2.0으로 조정한 MRS와 pH 2.0으로 조정한 MRS에 0.3% pepsin을 첨가한 배지를 이용하여 평가하였다. pH 조정 및 pepsin을 첨가하지 않은 기본 MRS를 대조군으로 사용하였다. 분리 균주를 MRS broth에서 37℃, 24시간 배양 후 원심분리(3,000 rpm, 10 min)하여 준비한 각 배지에 농도가 1×109 CFU/mL가 되도록 접종하여 37℃에서 배양하였다. 배양 후 0 hr, 3 hr의 배양액을 10배 단계 희석하여 MRS agar plate에 도말하고 혐기적 조건에서 37℃, 48 hr 동안 배양하여 생균수를 측정하였다. 측정된 생균수에 대한 내산성은 다음 수식과 같이 계산하였다.
분리 균주의 내담즙성은 0.3% bile salt가 첨가된 MRS broth를 이용하여 평가하였으며, 대조군으로는 bile salt를 첨가하지 않은 MRS broth를 사용하였다. 분리 균주를 MRS broth에서 37℃, 24 hr 배양 후 원심분리(3,000 rpm, 10 min)한 후, bile salt를 첨가하거나 첨가하지 않은 MRS broth를 각 1mL씩 분주하여 37℃에서 배양하였다. 배양 후 0 hr, 6 hr, 24 hr의 배양액을 10배 단계 희석하여 MRS agar plate에 도말하고 혐기적 조건에서 37℃, 48 hr 동안 배양하여 생균수를 측정하였다. 측정된 생균수에 대한 내담즙성은 다음 수식과 같이 계산하였다.
결과 및 고찰
1. 분변 시료 수집과 유산균 분리
본 연구에서는 임신 기간 중 프로바이오틱스를 섭취한 산모의 모유를 수유한 생후 40일 된 영아의 분변 시료로부터 새로운 유산균을 분리하고자 하였다. 시료를 배양한 결과, MRS agar plate에서 노란색을 띠며 둥근 형태의 매끄러운 가장자리를 가진 10개의 colony를 분리하였다. 이들에 대한 염기 서열 분석을 수행한 결과 다음과 같이 최종적으로 동정하였다. 10개의 분리주는 Lacticaseibacillus rhamnosus 1주, Lactobacillus gasseri 2주, Enterococcus faecalis 6주, Lacticaseibacillus paracasei 1주로 확인되었다. 이러한 구성은 영아 분변에서 유산균이 다양하게 존재함을 보여주며, 특히 초기 영아의 장내 미생물 정착 단계에서 Enterococcus 속이 우점한다는 선행연구의 관찰과 일치하였다(Al-Balawi M & Morsy FM 2020; Table 1).
2. 항산화능 평가
DPPH 라디칼 소거능은 자유라디칼을 중화하는 능력을 나타내는 지표로, 항산화 활성과 연관된 기능성을 탐색하는 데 널리 활용된다(Wang Y 등 2017). 이와 같은 DPPH 라디칼 소거능 기반의 항산화 평가 방식은 여러 유산균 균주에서도 보고된 바 있으며(Kim S 등 2022; Hu Y 등 2023), 이에 따라 본 연구에서도 분리 균주의 항산화 잠재력을 비교하였다.
그 결과는 Fig. 1과 같다. 양성대조군으로 사용한 L-ascorbic acid는 1 mM의 농도에서 95.43%의 자유 라디칼 소거 활성을 나타냈으며, 이와 비교하여 1번 균주는 96.66%, 2번 균주는 94.83%, 3번 균주는 95.80%, 4번 균주는 95.76%, 5번 균주는 95.73%, 6번 균주는 98.40%, 7번 균주는 90.85%, 8번 균주는 95.22%, 9번 균주는 93.34%, 10번 균주는 94.83%의 자유 라디칼 소거 활성을 나타냈다.

DPPH radical-scavenging activity of isolated lactic acid bacteria. The antioxidant activity of each isolate was evaluated by measuring its DPPH radical-scavenging ability (%). Data represent the mean±S.D. from four independent experiments, and L-ascorbic acid was used as the positive control.
이는 영아 분변 유래 유산균이 높은 DPPH 라디칼 소거능을 보였다는 선행 연구와도 일치하는 결과이며(Hyrslova I 등 2023), 10개의 균주 중 98.40%로 가장 높은 자유 라디칼 소거 활성을 보인 6번 균주 Lactobacillus gasseri BG-6를 선별하여 후속 실험에서 체내 안전성 평가에 사용하였다.
3. 항생제 내성 평가
선별된 L. gasseri BG-6 균주를 대상으로 E-test를 통해 총 9종의 항생제에 대한 MIC 값을 측정한 값은 Fig. 2와 같다. 측정된 MIC 값은 EFSA 기준에 따라 Lactobacillus acidophilus group의 cut-off 값을 적용하여 각 항생제에 대하여 감수성 및 내성이 존재하는지 판단하였다.

Antimicrobial susceptibility of Lactobacillus gasseri BG-6 determined by the E-test method. E-test strips showing inhibition ellipses of L. gasseri BG-6 against nine antibiotics (A). Minimum inhibitory concentration (MIC) values of L. gasseri BG-6 as determined by the E-test and interpreted according to the European Food Safety Authority (EFSA 2018) cut-off values (B). Amp, ampicillin; Van, vancomycin; Gen, gentamicin; Kan, kanamycin; Str, streptomycin; Ery, erythromycin; Cli, clindamycin; Tet, tetracycline; Chl, chloramphenicol. *Resistance according to EFSA (2018) criteria.
E-test 결과 MIC(mg/L) 값은 ampicillin 0.125, vancomycin 0.75, gentamicin 8, erythromycin 0.25, tetracycline 0.75로 기준 수치 미만으로 감수성을 보였다. streptomycin, chloramphenicol는 각 16과 4로 기준 수치와 동일한 경계값을 나타냈다. Kanamycin과 clindamycin은 각 256 이상과 4로 EFSA의 기준 수치인 64와 1을 초과하여 저항성을 보였다.
이와 같이 기준 수치를 초과하는 경우에는 저항성의 유전적 기초가 획득성인지 내재성인지에 따라 내재성 저항성을 증명할 경우 사용 가능하며, 획득성인 경우 유전적 돌연변이 발생으로 인하여 내성을 획득한 경우 사용이 가능하지만 추가된 유전자인 경우 수평 전이의 위험이 있다(Gueimonde M 등 2013). 따라서 L. gasseri BG-6 균주는 획득성 또는 내재성 내성 판단을 위한 추가 실험이 필요한 실정이다.
4. 용혈활성 평가
균주가 용혈활성을 가지고 있을 시 숙주의 적혈구를 파괴시키므로 이를 확인하는 안전성 평가가 요구된다(FAO & WHO 2002). 본 연구에서 분리한 균주의 용혈활성을 평가하기 위하여 5%의 sheep blood를 첨가한 TSA blood agar 배지에서 균주를 48 hr 동안 혐기적 환경에서 배양 후 투과광으로 용혈반응을 관찰하였다.
그 결과는 Fig. 3과 같다. 적혈구의 헤모글로빈이 메트헤모글로빈으로 산화되어 콜로니 주변 배지가 녹색으로 변색되는 α-hemolysis 또는 적혈구가 파괴되어 콜로니 주변에 투명한 환이 형성되는 β-hemolysis 양상은 관찰되지 않았으며, 이에 따라 γ-hemolysis(비용혈성)으로 확인되었다. 이는 본 균주가 적혈구를 용해시키는 독성 인자를 분비하지 않음을 의미하며, 여러 선행 연구에서 보고된 프로바이오틱스 균주들이 대체로 γ-hemolysis를 나타낸다는 결과와도 일치한다(Lee J 등 2022; Hyrslova I 등 2023).

Hemolytic activity of Lactobacillus gasseri BG-6 on 5% sheep blood agar. L. gasseri BG-6 was streaked onto TSA plates supplemented with 5% (v/v) sheep blood and incubated at 37℃ for 48 hr under microaerophilic conditions. No greenish (α-hemolysis) or clear zones (β-hemolysis) were observed around the colonies, indicating γ-hemolysis (non-hemolytic). These results confirm that L. gasseri BG-6 does not produce hemolytic toxins and supports its safety as a probiotics candidate.
5. BSH 활성 평가
BSH 활성의 경우 0.5% TDCA를 첨가한 MRS agar plate에서 48 hr 동안 37℃, 혐기적 조건에서 배양 후 콜로니 주변 배지의 불투명한 하얀색 침전환의 형성 여부로 판정하였다. 선별된 L. gasseri BG-6 균주를 배양한 결과는 Fig. 4에서 보이는 것과 같이 침전환이 관찰되지 않아 BSH 음성으로 확인되었다. 대조군으로 설정한 KCTC 3163(L. gasseri)의 경우에도 같은 조건에서 침전환이 관찰되지 않는 동일한 결과를 보였다.
Bile salt hydrolase (BSH) activity of Lactobacillus gasseri BG-6 on MRS agar supplemented with 0.5% TDCA. Growth of L. gasseri BG-6 and the reference strain (L. gasseri KCTC 3163) was compared on MRS agar (left) and MRS agar containing 0.5% TDCA (right). Both strains showed normal growth; however, no precipitation or halo formation was observed on TDCA-containing plates, indicating absence of BSH activity in BG-6 under these conditions. Data represent three independent experiments.
BSH 양성의 경우 deconjugation된 bile salt의 2차 대사 산물이 독성을 가질 수 있으므로 과다 섭취하지 않도록 주의 권고가 필요하다(Ridlon JM 등 2014). 본 연구에서 분리한 균주의 경우 BSH 음성으로 확인되어 이러한 담즙산 변환 경로의 관여 가능성은 낮은 것으로 보인다.
6. 내산성 및 내담즙성 평가
프로바이오틱스를 섭취한 후 체내에서 기능을 발휘하기 위해서는 소화기관의 조건에서 생존해야 한다(Mainville I 등 2005). 이에 본 연구에서는 분리된 균주의 프로바이오틱스 활성 평가를 위해 내산성 및 내담즙성을 분석하였다.
내산성 평가는 pH 7.0, pH 2.0 및 pH 2.0에 0.3% pepsin을 첨가한 조건의 MRS broth에서 0 hr과 3 hr 후의 생균수를 측정하여 생존율을 산출하여 Fig. 5에 나타내었다. 그 결과, L. gasseri BG-6 균주는 0 hr 기준 생균수는 각 7.74, 7.70, 7.77 log CFU/mL로 유사한 수준을 보였으며, 3 hr 경과 후에는 각 8.54, 7.18, 7.15 log CFU/mL로 측정되었다. 이를 바탕으로 계산한 내산성 생존율은 각 110.31%, 93.19%, 91.95%의 높은 수치를 보였다.

Acid and pepsin tolerance of Lactobacillus gasseri BG-6. Acid and pepsin tolerance of L. gasseri BG-6 after incubation at pH 7.0, pH 2.0, and in 0.3% pepsin solution for 3 hr . Cell viability was measured as viable cell counts (log CFU/mL) (A), and survival rates (%) were calculated relative to the initial cell count at 0 h (B). Both isolates maintained high viability under acidic and pepsin conditions, indicating strong tolerance to simulated gastric environments. Data are presented as mean±S.D. from three independent experiments.
내담즙성 평가는 0.3% bile salt가 첨가된 MRS broth에서 0, 6, 24 hr 동안의 생균수의 변화는 Fig. 6과 같다. L. gasseri BG-6균주의 대조군인 일반 MRS broth에서의 생균수는 0, 6, 24 hr에서 각 9.17, 9.71, 9.85 log CFU/mL로 시간의 흐름에 따라 증가하였으며, 동일 시간대의 0.3% bile salt 첨가 조건에서는 각 6.83, 5.80, 4.12 log CFU/mL로 나타났다. 이에 따른 생존율은 대조군에서 6 hr 105.89%, 24 hr 107.37%로 산출되었으며, 담즙 첨가 조건에서는 각 84.83%, 60.33%로 확인되었다.

Bile salt tolerance of Lactobacillus gasseri BG-6. Cell viability was measured as viable cell counts (log CFU/mL) (A) and survival rates (%) were calculated relative to the initial cell count at 0 hr (B) after incubation in MRS broth and MRS broth containing 0.3% bile salts for 6 hr and 24 hr. L. gasseri BG-6 maintained stable growth in MRS, while exposure to bile salts resulted in reduced viability over time. Data are presented as mean±S.D. from three independent experiments.
이러한 위장관 조건에서도 생균수의 유지 및 증식이 관찰된 점은 해당 균주가 장내 위산 및 담즙 환경에서도 안정적으로 정착하고 기능을 수행할 수 있는 능력을 지니고 있음을 시사한다. 이는 영아 분변 유래 균주가 위산과 담즙 조건에서 높은 생존율을 보였다고 보고한 선행 연구들과도 유사한 경향을 나타낸다(Kim HS 등 2006; Rubio R 등 2014; Wu JJ 등 2023).
요약 및 결론
본 연구는 임신 기간 중 프로바이오틱스를 섭취한 산모의 모유를 수유한 영아의 분변으로부터 유산균을 분리 및 동정하고, 선별 균주의 프로바이오틱스 잠재력과 안전성을 평가하였다. 혐기 조건의 MRS agar plate에서 형태학적으로 상이한 10개의 집락을 확보하였으며, DPPH 라디칼 소거법 스크리닝에서 L. gasseri BG-6가 1 mM L-ascorbic acid(95.43%) 대비 가장 높은 소거능(98.40%)을 보여 후속 평가 대상 균주로 선정하였다. 이러한 항산화 활성은 영아 분변 유래 LAB가 높은 DPPH 라디칼 소거능을 보였다고 보고한 선행 연구들과도 일치하였다.
안전성 평가는 항생제 감수성, 용혈성, BSH 활성을 중심으로 수행하였다. E-test로 평가한 MIC 결과 ampicillin 0.125 mg/L, vancomycin 0.75 mg/L, gentamicin 8 mg/L, erythromycin 0.25 mg/L, tetracycline 0.75 mg/L에서 감수성을 보였고, streptomycin 16 mg/L, chloramphenicol 4 mg/L은 경계값을 나타냈다. 반면 kanamycin>256 mg/L과 clindamycin 4mg/L에서는 저항성이 확인되었다. 5% sheep blood가 첨가된 TSA에서 α-hemolysis 또는 β-hemolysis가 관찰되지 않아 γ-hemolysis(비용혈성)으로 판정되었으며, 0.5% TDCA를 첨가한 MRS agar plate에서 콜로니 주변의 불투명한 침전환이 형성되지 않아 BSH 음성으로 확인되었다. 이러한 결과 역시 기존 보고된 안전한 영아 분변 유래 LAB의 특성과 부합하였다.
기능성 측면에서는 위장관 유사 조건에서의 생존성을 확인하였다. pH 7.0과 0.3% pepsin을 첨가하지 않거나 첨가한 pH 2.0 조건의 MRS broth에서 생균수는 0 hr에서 각 7.74, 7.70, 7.77 log CFU/mL, 3 hr에서 8.54, 7.18, 7.15 log CFU/mL로 측정되었다. 내산성은 각 110.31%, 93.19%, 91.95%로 나타났다. 0.3% bile salt를 첨가하지 않거나 첨가한 조건의 MRS broth에서 생균수는 0시간에서 각 9.17, 6.83 log CFU/mL, 6시간에서 각 9.71, 5.80 log CFU/mL, 24 hr에서 각 9.85, 4.12 log CFU/mL로 측정되었다. 6 hr에서 각 105.89, 84.83%로 산출되었으며, 24 hr에서 각 107.37, 60.33%로 확인되었다. 이는 선행연구에서 보고된 L. gasseri 및 영아 분변 유래 LAB의 우수한 산 및 담즙 내성과 유사한 경향으로, BG-6가 실제 위장관 통과 과정에서도 생존 가능성이 높다는 점을 시사한다.
이에 따라 모유 수유 영아 분변 유래 L. gasseri BG-6는 높은 항산화능과 비용혈성 및 BSH 음성, 우수한 내산성 및 내담즙성을 동시에 갖춘 건강기능식품용 프로바이오틱스 소재로서의 잠재력이 확인되었다. 다만, 항생제 감수성 평가에서 kanamycin과 clindamycin에 대한 저항성이 관찰되었으며, 이는 해당 내성의 획득성 여부를 확인하기 위한 추가적인 유전학적 검증이 필요함을 시사한다. 전장유전체 분석을 기반으로 한 HGTree 또는 유사한 비교유전체 도구를 활용하면 내재성과 획득성 내성의 구분이 가능하므로, 이러한 후속 연구는 BG-6의 안전성 프로파일을 보다 명확하게 확립하는 데 기여할 것이다. 특히 BG-6는 임신 산모의 프로바이오틱스 섭취-모유-영아 장내 미생물군으로 이어지는 특수한 미생물 전이 경로를 통해 형성된 균주로, 기존의 영아 분변 유래 L. gasseri 연구와는 기원적·생태적 배경이 다르다(Kim HS 등 2006; Hyrslova I 등 2023). 이러한 독특한 유래는 BG-6가 기존 보고된 균주와 차별화된 기능적 특성을 가질 가능성을 보여주며, 균주의 유전적 안정성과 내성 기원을 규명하는 연구는 BG-6의 안전성 확보 및 산업적 활용성 확대에 중요한 근거가 될 것이다.
Acknowledgments
본 연구는 과학기술정보통신부가 지원하고 한국연구재단(NRF)이 수행하는 기본연구사업(NRF-2021R1F1A1049752)의 지원을 받아 수행되었다.
REFERENCES
-
Al-Balawi M, Morsy FM (2020) Enterococcus faecalis is a better competitor than other lactic acid bacteria in the initial colonization of colon of healthy newborn babies at first week of their life. Front Microbiol 11: 2017.
[https://doi.org/10.3389/fmicb.2020.02017]

-
Ali M, Amin A, Abbas Z (2025) Efficacy of Lacticaseibacillus rhamnosus probiotic strains in treating chromate induced dermatitis. Sci Rep 15(1): 8796.
[https://doi.org/10.1038/s41598-025-93732-9]

-
Bhatia A, Sharma D, Mehta J, Kumarasamy V, Begum MY, Siddiqua A, Sekar M, Subramaniyan V, Wong LS, Mat Rani NNI (2025) Probiotics and synbiotics: Applications, benefits, and mechanisms for the improvement of human and ecological health. J Multidiscip Healthc 18: 1493-1510.
[https://doi.org/10.2147/JMDH.S501056]

-
Davis EC, Castagna VP, Sela DA, Hillard MA, Lindberg S, Mantis NJ, Seppo AE, Järvinen KM (2022) Gut microbiome and breast-feeding: Implications for early immune development. J Allergy Clin Immunol 150(3): 523-534.
[https://doi.org/10.1016/j.jaci.2022.07.014]

-
Davoodabadi A, Dallal MMS, Lashani E, Ebrahimi MT (2015) Antimicrobial activity of Lactobacillus spp. isolated from fecal flora of healthy breast-fed infants against diarrheagenic Escherichia coli. Jundishapur J Microbiol 8(12): e27852.
[https://doi.org/10.5812/jjm.27852]

-
EFSA Panel on Additives and Products or Substances used in Animal Feed (FEEDAP), Rychen G, Aquilina G, Azimonti G, Bampidis V, Bastos MDL, Bories G, Chesson A, Cocconcelli PS, Flachowsky G, Gropp J, Kolar B, Kouba M, López-Alonso M, Puente SL, Mantovani A, Mayo B, Ramos F, Saarela M, Villa RE, Wallace RJ, Wester P, Glandorf B, Herman L, Kärenlampi S, Aguilera J, Anguita M, Brozzi R, Galobart J (2018) Guidance on the characterization of microorganisms used as feed additives or as production organisms. EFSA J 16(3): e05206.
[https://doi.org/10.2903/j.efsa.2018.5206]

- FAO, WHO (2002) Guidelines for the Evaluation of Probiotics in Food. Food and Agriculture Organization of the United Nations and World Health Organization, Rome, Italy.
-
Fontana L, Bermudez-Brito M, Plaza-Diaz J, Muñoz-Quezada S, Gil A (2013) Sources, isolation, characterisation and evaluation of probiotics. Br J Nutr 109(S2): S35-S50.
[https://doi.org/10.1017/S0007114512004011]

-
Gueimonde M, Sánchez B, de los Reyes-Gavilán CG, Margolles A (2013) Antibiotic resistance in probiotic bacteria. Front Microbiol 4: 202.
[https://doi.org/10.3389/fmicb.2013.00202]

-
Gupta V, Garg R (2009) Probiotics. Indian J Med Microbiol 27(3): 202-209.
[https://doi.org/10.4103/0255-0857.53201]

-
Hou K, Wu ZX, Chen XY, Wang JQ, Zhang D, Xiao C, Zhu D, Koya JB, Wei L, Li J, Chen ZS (2022) Microbiota in health and diseases. Signal Transduct Target Ther 7(1): 135.
[https://doi.org/10.1038/s41392-022-00974-4]

-
Hu Y, Zhao Y, Jia X, Liu D, Huang X, Wang C, Zhu Y, Yue C, Deng S, Lyu Y (2023) Lactic acid bacteria with a strong antioxidant function isolated from “Jiangshui,” pickles, and feces. Front Microbiol 14: 1163662.
[https://doi.org/10.3389/fmicb.2023.1163662]

-
Hyrslova I, Drab V, Cihlar J, Krausova G, Mrvikova I, Kana A, Stetina J, Musilova S (2023) Functional and probiotic characterization of newly isolated strains from infant feces and breast milk. Fermentation 9(11): 960.
[https://doi.org/10.3390/fermentation9110960]

-
Jang SE, Min SW (2019) Lactobacillus sakei S1 improves colitis induced by 2,4,6-trinitrobenzene sulfonic acid by the inhibition of NF-κB signaling in mice. J Microbiol Biotechnol 30(1): 71-78.
[https://doi.org/10.4014/jmb.1907.07050]

-
Jeong JW, Lee D, Kim H, Gwon H, Lee K, Kim JY, Shim JJ, Lee JH (2025) Lacticaseibacillus paracasei HP7 improves gastric emptying by modulating digestive factors in a loperamide-induced functional dyspepsia mouse model. J Microbiol Biotechnol 35: e2412035.
[https://doi.org/10.4014/jmb.2412.12035]

-
Johnson CL, Versalovic J (2012) The human microbiome and its potential importance to pediatrics. Pediatrics 129(5): 950-960.
[https://doi.org/10.1542/peds.2011-2736]

-
Khanzadeh M, Hoseinifar SH, Yazici M, Van Doan H (2025) Fermentation of Sargassum ilicifolium with probiotics (Lactobacillus plantarum and Saccharomyces cerevisiae) enhances growth, immunity, and gene expression in rainbow trout before and after challenge with Streptococcus iniae. Probiotics Antimicrob Proteins 1-25.
[https://doi.org/10.1007/s12602-025-10502-9]

-
Kim HS, Jeong SG, Ham JS, Chae HS, Lee JM, Ahn CN (2006) Antioxidative and probiotic properties of Lactobacillus gasseri NLRI-312 isolated from Korean infant feces. Asian-Aust J Anim sci 19(9): 1335-1341.
[https://doi.org/10.5713/ajas.2006.1335]

-
Kim S, Lee JY, Jeong Y, Kang CH (2022) Antioxidant activity and probiotic properties of lactic acid bacteria. Fermentation 8(1): 29.
[https://doi.org/10.3390/fermentation8010029]

-
Lee J, Kim S, Kang CH (2022) Screening and probiotic properties of lactic acid bacteria with potential immunostimulatory activity isolated from Kimchi. Fermentation 9(1): 4.
[https://doi.org/10.3390/fermentation9010004]

-
Li W, Xu M, Liu Y, Zhang S, Wang J, Zhang Z, Xiao G, Wang R, Zhang J, Xue H (2025) Lactiplantibacillus plantarum GOLDGUT-HNU082 alleviates CUMS-induced depressive-like behaviors in mice by modulating the gut microbiota and neurotransmitter levels. Foods 14(5): 813.
[https://doi.org/10.3390/foods14050813]

-
Mainville I, Arcand Y, Farnworth ER (2005) A dynamic model that simulates the human upper gastrointestinal tract for the study of probiotics. Int J Food Microbiol 99(3): 287-296.
[https://doi.org/10.1016/j.ijfoodmicro.2004.08.020]

-
Milani C, Duranti S, Bottacini F, Casey E, Turroni F, Mahony J, Belzer C, Delgado Palacio S, Arboleya Montes S, Mancabelli L, Lugli GA, Miguel Rodriguez J, Bode L, de Vos W, Gueimonde M, Margolles A, van Sinderen D, Ventura M (2017) The first microbial colonizers of the human gut: Composition, activities, and health implications of the infant gut microbiota. Microbiol Mol Biol Rev 81(4): e00036-17.
[https://doi.org/10.1128/MMBR.00036-17]

-
Rautava S (2016) Early microbial contact, the breast milk microbiome and child health. J Dev Orig Health Dis 7(1): 5-14.
[https://doi.org/10.1017/S2040174415001233]

-
Ridlon JM, Kang DJ, Hylemon PB, Bajaj JS (2014) Bile acids and the gut microbiome. Curr Opin Gastroenterol 30(3): 332-338.
[https://doi.org/10.1097/MOG.0000000000000057]

-
Rinninella E , Raoul P, Cintoni M, Franceschi F, Miggiano GAD, Gasbarrini A, Mele MC (2019) What is the healthy gut microbiota composition? A changing ecosystem across age, environment, diet, and diseases. Microorganisms 7(1): 14.
[https://doi.org/10.3390/microorganisms7010014]

-
Rubio R, Jofré A, Martín B, Aymerich T, Garriga M (2014) Characterization of lactic acid bacteria isolated from infant feces as potential probiotic starter cultures for fermented sausages. Food Microbiol 38: 303-311.
[https://doi.org/10.1016/j.fm.2013.07.015]

-
Schultz M, Göttl C, Young RJ, Iwen P, Vanderhoof JA (2004) Administration of oral probiotic bacteria to pregnant women causes temporary infantile colonization. J Pediatr Gastroenterol Nutr 38(3): 293-297.
[https://doi.org/10.1002/j.1536-4801.2004.tb12165.x]

-
Sender R, Fuchs S, Milo R (2016) Revised estimates for the number of human and bacteria cells in the body. PLoS Biol 14(8): e1002533.
[https://doi.org/10.1371/journal.pbio.1002533]

-
Shim YH, Lee SJ, Lee JW (2016) Antimicrobial activity of lactobacillus strains against uropathogens. Pediatr Int 58(10): 1009-1013.
[https://doi.org/10.1111/ped.12949]

-
Slover CM, Danziger L (2008) Lactobacillus: A review. Clin Microbiol Newsl 30(4): 23-27.
[https://doi.org/10.1016/j.clinmicnews.2008.01.006]

-
Tuomola EM, Salminen SJ (1998) Adhesion of some probiotic and dairy Lactobacillus strains to Caco-2 cell cultures. Int J Food Microbiol 41(1): 45-51.
[https://doi.org/10.1016/S0168-1605(98)00033-6]

-
Wang X, Wang W, Lv H, Zhang H, Liu Y, Zhang M, Wang Y, Tan Z (2021) Probiotic potential and wide-spectrum antimicrobial activity of lactic acid bacteria isolated from infant feces. Probiotics Antimicrob Proteins 13(1): 90-101.
[https://doi.org/10.1007/s12602-020-09658-3]

-
Wang Y, Wu Y, Wang Y, Xu H, Mei X, Yu D, Wang Y, Li W (2017) Antioxidant properties of probiotic bacteria. Nutrients 9(5): 521.
[https://doi.org/10.3390/nu9050521]

-
Wu JJ, Zhou QY, Liu DM, Xiong J, Liang MH, Tang J, Xu YQ (2023) Evaluation of the safety and probiotic properties of Lactobacillus gasseri LGZ1029 based on whole genome analysis. LWT-Food Sci Technol 184: 114759.
[https://doi.org/10.1016/j.lwt.2023.114759]

-
Wu Y, Li C, Geng Z, Wang L, Wang S, Zhang D, Li D, Meng F (2024) Anti-colon cancer effects of lysate from potential probiotic yeast strains derived from human breast milk. Probiotics Antimicrob Proteins 17(6): 4744-4763.
[https://doi.org/10.1007/s12602-024-10410-4]

-
Zuo F, Yu R, Feng X, Chen L, Zeng Z, Khaskheli GB, Ma H, Chen S (2016) Characterization and in vitro properties of potential probiotic Bifidobacterium strains isolated from breast-fed infant feces. Ann Microbiol 66(3): 1027-1037.
[https://doi.org/10.1007/s13213-015-1187-x]


